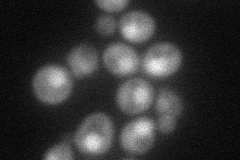
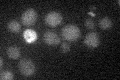

View description
DDK (Dbf4-dependent kinase) catalytic subunit required for firing origins and replication fork progression in mitosis through phosphorylation of Mcm2-7p complexes and Cdc45p; kinase activity correlates with cyclical DBF4 expression
Localization:
Intensity:
Fold change:
Significance:
-
C’ GFP library in SD

nucleus23.11 -
N' NOP1pr-GFP in SD

cytosol,nucleus62.5219 -
N' TEF2pr-mCherry in SD
nucleus50.2846 -
N' NATIVEpr-GFP in SD

nucleus23.382 -
N' TEF2pr-VC and Cyto-VN in SD

cytosol31.6529 -
C’ GFP library in SD+DTT

nucleus29.381.27No -
C’ GFP library in SD+H2O2

nucleus28.441.23No -
C’ GFP library in Starvation Media
nucleus21.830.94No -
C’ GFP library on the background of Pup2-DaMP

nucleus -
C’ GFP library on the background of CCT mutant

nucleus20.5840.890424No
